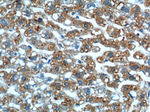
GPR177 Antibody in Immunohistochemistry (Paraffin) (IHC (P))
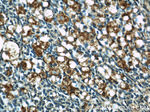
GPR177 Antibody in Immunohistochemistry (Paraffin) (IHC (P))

Search
Proteintech
GPR177 Polyclonal Antibody
{{$productOrderCtrl.translations['antibody.pdp.commerceCard.promotion.promotions']}}
{{$productOrderCtrl.translations['antibody.pdp.commerceCard.promotion.viewpromo']}}
{{$productOrderCtrl.translations['antibody.pdp.commerceCard.promotion.promocode']}}: {{promo.promoCode}} {{promo.promoTitle}} {{promo.promoDescription}}. {{$productOrderCtrl.translations['antibody.pdp.commerceCard.promotion.learnmore']}}

Please note: We are reviewing Western blot images included in the antibody testing data in our catalog, including those provided by third parties. Unless expressly labeled or annotated as “raw-unedited”, Western blot images included in the antibody testing data in our catalog may have been edited, optimized or otherwise adjusted for presentation.
产品信息
17950-1-AP
种属反应
已发表种属
宿主/亚型
分类
类型
抗原
偶联物
形式
浓度
规格
纯化类型
保存液
内含物
保存条件
运输条件
产品详细信息
Immunogen sequence: LIAPGPTTA VSYMSVKCVD ARKNHHKTKW FVPWGPNHCD KIRDIEEAIP REIEANDIVF SVHIPLPHME MSPWFQFMLF ILQLDIAFKL NNQIRENAEV SMDVSLAYRD DAFAEWTEMA HERVPRKLKC TFTSPKTPEH EGRYYECDVL PFMEIGSVAH KFYLLNIRLP VNEKKKINVG IGEIKDIRLV GIHQNGGFTK VWFAMKT (34-239 aa encoded by BC110826)
靶标信息
Regulates Wnt proteins sorting and secretion in a feedback regulatory mechanism. This reciprocal interaction plays a key role in the regulation of expression, subcellular location, binding and organelle-specific association of Wnt proteins. Plays also an important role in establishment of the anterior-posterior body axis formation during development. [UniProt]
仅用于科研。不用于诊断过程。未经明确授权不得转售。
生物信息学
蛋白别名: evenness interrupted homolog; EVI; G protein-coupled receptor 177; Integral membrane protein GPR177; Protein evenness interrupted homolog; Protein wntless homolog; Putative NF-kappa-B-activating protein 373
基因别名: 5031439A09Rik; AI173978; AI987742; C1orf139; GPR177; UNQ85/PRO18667; WLS
UniProt ID: (Mouse) Q6DID7, (Rat) Q6P689
Entrez Gene ID: (Mouse) 68151, (Rat) 362065




